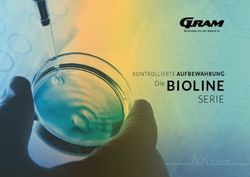
Die BIOLINE SERIE KONTROLLIERTE AUFBEWAHRUNG - Gram BioLine

Mandanten-Informationsbrief - zum 1. März 2021 - Steuerkanzlei Feucht
←
→
Transkription von Seiteninhalten
Wenn Ihr Browser die Seite nicht korrekt rendert, bitte, lesen Sie den Inhalt der Seite unten
Mandanten-Informationsbrief
zum 1. März 2021
Inhalt
1 Hinweise zur aktuellen Förderung durch die Überbrückungshilfe III
2 Neustarthilfe für Soloselbständige
3 Drittes Corona-Steuerhilfegesetz
4 Kosten für Corona-Tests
5 Privatnutzung eines Firmenwagens
6 Sofortabschreibung für digitale Wirtschaftsgüter geplant
7 Verlängerung der Steuererklärungsfristen
8 Erleichterungen für freiwillige Helfer in Impfzentren
9 Weitere Informationen
Allgemeines
Mit dem vorliegenden Mandanten-Informationsbrief möchten wir Sie wieder über verschie-
dene interessante und aktuelle Themen informieren. Ein Schwerpunkt des heutigen Infor-
mationsbriefes liegt in den aktuellen „Corona-Förderungen“ des Bundes.
Der nächste Mandanten-Informationsbrief wird am 01. Mai 2021 erscheinen.1. Hinweise zur aktuellen Förderung Hinweis: Eine „Splittung“ der Förderung ist
durch die Überbrückungshilfe III nicht möglich. Es kann z.B. nicht für den
November 2020 die entsprechende No-
Wer ist antragsberechtigt? vemberhilfe und für den Dezember 2020
dann zu der Förderung nach der Überbrü-
Begünstigt sind grundsätzlich – anders als
ckungshilfe III optiert werden.
bei den Überbrückungshilfen I und II – nun-
mehr alle Unternehmen mit einem Jahres-
Förderfähige Kosten
umsatz von bis zu 750 Mio. €, sofern diese
in einem Monat einen Umsatzeinbruch von Bei der Überbrückungshilfe III handelt es
mindestens 30 Prozent im Vergleich zum sich (wie in den ersten beiden Phasen) um
Referenzmonat im Jahr 2019 erlitten ha- einen Fixkostenzuschuss für abschlie-
ben. Sie können eine Förderung im Rah- ßend genannte Kostenarten. Daher be-
men der förderfähigen Maßnahmen der stimmt sich die Höhe der Überbrückungs-
Überbrückungshilfe III für den betreffenden hilfe III auch maßgeblich nach den entstan-
Monat beantragen. denen Fixkosten. Diese werden abhängig
vom Umsatzrückgang in prozentualer
Unternehmen, die zwischen dem 1. Januar
Höhe gefördert.
2019 und dem 30. April 2020 gegründet
wurden, können einen alternativen Ver- Hinweis: Die Förderrichtlinien sehen hier
gleichsumsatz bilden, z.B. den durch- einen strengen Katalog maßgeblicher be-
schnittlichen monatlichen Umsatz des Jah- trieblicher Fixkosten vor. Gerne lassen wir
res 2019. Ihnen hier ein entsprechendes Muster zur
Ermittlung der für Sie maßgeblichen Fix-
Achtung: Wie auch bei den vorgehenden
kosten zukommen.
Überbrückungshilfen I und II gilt: Eine Aus-
zahlung an Unternehmen, die ihren Ge- Für gewisse Branchen sind Besonderhei-
schäftsbetrieb dauerhaft eingestellt oder ten bei der Ermittlung der Fixkosten vorge-
die Insolvenz beantragt haben, ist ausge- sehen, dies betrifft:
schlossen. Zudem darf sich das Unterneh-
• Unternehmen der Reisebranche,
men am 31.12.2019 nicht in wirtschaftli-
• Unternehmen der Veranstaltungs-
chen Schwierigkeiten befunden haben.
und Kulturbranche,
Ausschluss bei Inanspruchnahme No- • Unternehmen im Einzelhandel, so-
vember-/Dezemberhilfe weit diese im Jahr 2020 einen Ver-
lust erwirtschaftet haben sowie
Ein Unternehmen darf daneben für die För- • Unternehmen der pyrotechnischen
dermonate November und Dezember Industrie.
2020 keine Überbrückungshilfe III beantra-
gen, wenn bereits November- oder Dezem- Höhe der Förderung
berhilfe gewährt wurde. Sollten bereits
In welcher Höhe nun die obig zu Grunde
Leistungen nach der Überbrückungshilfe II
gelegten Fixkosten im Rahmen der Über-
beantragt worden sein, werden die entspre-
brückungshilfe III konkret gefördert = er-
chenden Leistungen für diese Monate an-
stattet werden, hängt wiederum vom kon-
gerechnet.
kreten Umsatzeinbruch im Betrachtungs-
zeitraum (November 2020 bzw. Januar
2021 bis Juni 2021) ab.
2Hierbei greift eine Staffelungsregelung wie 2. Neustarthilfe für Soloselbständige
folgt:
Soloselbständigen wird im Rahmen der
• Umsatzeinbruch > 70 % Überbrückungshilfe III eine einmalige Be-
Erstattung von 90 % der Fixkosten triebskostenpauschale von bis zu 7.500 €
• Umsatzeinbruch ≥ 50 % bis ≤ 70 % gezahlt, wenn sie ansonsten keine Fixkos-
ten in der Überbrückungshilfe III geltend
Erstattung von 60 % der Fixkosten machen. Damit soll insbesondere Künst-
lern und Kulturschaffenden geholfen wer-
• Umsatzeinbruch ≥ 30 % bis < 50 % den, welche i.d.R. nur geringe betriebliche
Erstattung von 40 % der Fixkosten Fixkosten haben.
• Umsatzeinbruch < 30 % Achtung: Voraussetzung ist, dass im Rah-
keine Erstattung men der Überbrückungshilfe keine weite-
ren Kosten geltend gemacht werden. D.h.
Hinweis
Neustarthilfe und Überbrückungshilfe III
Der jeweilige Fördersatz ist hierbei pro Mo- schließen sich gegenseitig aus.
nat zu ermitteln.
Die einmalige Betriebskostenpauschale
Antragsberechtigte sollen bei ihrem Erstan- steht – wie die Überbrückungshilfen insge-
trag als Vorauszahlung auf die endgültige samt –Soloselbständigen zu, die ihr Ein-
Förderung durch die Bewilligungsstelle kommen im Referenzzeitraum (im Normal-
eine Abschlagszahlung in Höhe von 50 % fall das Jahr 2019) zu mindestens 51 Pro-
der beantragten Förderung, jedoch höchs- zent aus ihrer selbständigen Tätigkeit er-
tens 100.000 € für einen Monat erhalten. zielt haben.
Der maximale Zuschuss beträgt 1,5 Millio-
Die volle Betriebskostenpauschale wird ge-
nen € pro Monat
währt, wenn der Umsatz des Soloselbstän-
digen während der sechsmonatigen Lauf-
Beantragung
zeit Januar 2021 bis Juni 2021 im Ver-
Voraussetzung für die Beantragung der gleich zu einem sechsmonatigen Referen-
Überbrückungs-hilfe III ist nicht, dass be- zumsatz 2019 um 60 Prozent oder mehr
reits Überbrückungshilfe I und/oder Über- zurückgegangen ist.
brückungshilfe II beantragt bzw. ausgezahlt
wurde. Die Förderprogramme laufen inso- Der sechsmonatige Referenzumsatz 2019
wird ermittelt, indem der durchschnittliche
weit unabhängig voneinander – eine Dop-
Monatsumsatz 2019 (also über die gesam-
pelförderung ist jedoch ausgeschlossen.
ten 12 Monate) berechnet und dann mit
Anträge auf Gewährung der Überbrü- dem Faktor sechs multipliziert wird. Im Er-
ckungshilfe III können seit dem 10. Februar gebnis ist der Referenzumsatz daher die
2021 gestellt werden. Hälfte des Jahresumsatzes 2019. In Neu-
Achtung: Der Antrag ist zwingend durch ei- gründungsfällen greifen wiederum alterna-
nen prüfenden Dritten (z.B. Steuerberater) tive Berechnungsmethoden.
im Namen des Antragsstellenden über eine
digitale Schnittstelle an die Bewilligungs-
stellen der Länder einzureichen.
3Anrechnung von Umsätzen Hinweis: Die Begünstigten werden bei Be-
antragung zu einer Endabrechnung durch
Sollte der Umsatz während der sechsmo-
Selbstprüfung nach Ablauf des Förder-
natigen Laufzeit bei über 40 Prozent des
zeitraums verpflichtet. Im Rahmen dieser
sechsmonatigen Referenzumsatzes liegen,
Selbstprüfung sind auch Einkünfte aus ab-
sind die Vorschusszahlungen anteilig so
hängiger Beschäftigung – sofern vorhan-
zurückzuzahlen, dass in Summe der er-
den – zu den Umsätzen aus selbständiger
zielte Umsatz und die Förderung 90 Pro-
Tätigkeit zu addieren. Zur Vermeidung von
zent des Referenzumsatzes nicht über-
Subventionsbetrug wurden bereits stich-
schreiten.
probenhafte Nachprüfungen angekündigt.
So können beispielsweise bei einem tat- Die genauen Details von Erklärungs- und
sächlichen Umsatz von 60 Prozent des Re- Selbstprüfungspflichten stehen jedoch
ferenzumsatzes im Betrachtungszeitraum noch nicht fest.
30 Prozent des Referenzumsatzes als För-
In einem zweiten, späteren Antrags-
derung behalten werden, die Differenz zur
schritt wird das Antragsverfahren auch ge-
ausgezahlten Förderung (20 Prozent) ist
öffnet für:
zurückzuzahlen.
Liegt der erzielte Umsatz bei 90 Prozent • Soloselbständige, die neben ihren
oder mehr, so ist die Neustarthilfe voll- freiberuflichen und/oder gewerbli-
ständig zurückzuzahlen. chen Umsätzen auch anteilige Um-
sätze aus Personengesellschaften
Wenn die so errechnete Rückzahlung un- (PartG, KG, GbR, OHG) erzielen;
terhalb einer Schwelle von 250 Euro liegt,
• Soloselbständige, die anteilige Um-
ist keine Rückzahlung erforderlich.
sätze aus Personengesellschaften
erzielen und alle ihre selbständigen
Antrag Neustarthilfe
Umsätze über diese Gesellschaften
Bei der Neustarthilfe ist ein zweigestuftes erzielen und
Antragsverfahren vorgesehen: • Kapitalgesellschaften mit einer Ge-
In einem ersten Antragsschritt kann die sellschafterin bzw. einem Gesell-
Neustarthilfe seit dem 16. Februar 2021 schafter (Ein-Personen-GmbH, Ein-
von natürlichen Personen beantragt wer- Personen-UG (haftungsbe-
den, die ihre selbständigen Umsätze als schränkt)) bzw. einer Aktionärin o-
Freiberuflerinnen und Freiberufler sowie der einem Aktionär (Ein-Personen-
als Gewerbetreibende für die Berechnung AG).
der Neustarthilfe zugrunde legen möchten. Dieses zweite Antragsverfahren kann (vo-
Achtung: Die „Neustarthilfe“ für Solo- raussichtlich) durch uns als prüfende Dritte
selbstständige im ersten Antragsschritt in durchgeführt bzw. unterstützt werden.
Höhe von bis zu 7.500 Euro kann nur direkt Achtung: Anträge im zweiten Antragsver-
durch Sie selbst als Betroffener beantragt fahren sind aktuell noch nicht möglich, wir
werden. Für die Anmeldung zum Direktan- informieren Sie sobald dieses möglich ist.
trag benötigen Sie ein ELSTER-Zertifikat. Wurde ein Antrag im ersten Antragsschritt
gestellt, ist eine Erweiterung des Antrags
im Rahmen des zweiten Antragsverfahrens
nicht möglich!
43. Drittes Corona-Steuerhilfegesetz Der BFH hat hier in einer aktuellen Ent-
scheidung noch einmal die Grundsätze auf-
Ende Februar hat der Bundestag das Dritte
gezeigt.
Corona-Steuerhilfegesetz verabschiedet.
Es enthält im Wesentlichen folgende Maß- Ausgangsfall war ein Gesellschafter-Ge-
nahmen: schäftsführer einer GmbH. Dieser gab an,
den ihm zur Verfügung gestellten Firmen-
• Die Gewährung des ermäßigten Um- wagen ausschließlich für betriebliche, nicht
satzsteuersatz in Höhe von 7 %für er- jedoch für private Zwecke zu nutzen.
brachte Restaurant-und Verpflegungs-
dienstleistungen wird über den Der BFH stellte klar: Ob der Steuerpflich-
30.06.2021 hinaus bis zum tige dienstliche Fahrzeuge, welche zu pri-
31.12.2022(!)verlängert. Getränke vaten Zwecken zur Verfügung stehen, auch
bleiben hiervon jedoch ausgenommen. tatsächlich privat nutzt, ist für die Besteue-
• Für jedes im Jahr 2021 kindergeldbe- rung des Nutzungsvorteils unerheblich.
rechtigte Kind wird ein Kinderbonus Die Behauptung des Steuerpflichtigen, das
von 150 Euro gewährt. betriebliche Fahrzeug nicht für Privatfahr-
• Der steuerliche Verlustrücktrag wird für ten genutzt, oder Privatfahrten ausschließ-
die Jahre 2020 und 2021 nochmals er- lich mit anderen Fahrzeugen durchgeführt
weitert und auf 10 Mio. Euro bzw. 20 zu haben, genügt damit nicht, um die Be-
Mio. Euro (bei Zusammenveranla- steuerung des Nutzungsvorteils auszu-
gung) angehoben. Dies gilt auch beim schließen. Diese Grundsätze gelten auch
vorläufigen Verlustrücktrag für 2020. für Alleingesellschafter-Geschäftsführer,
Die Zustimmung des Bundesrates steht die für ihre GmbH als Arbeitnehmer tätig
werden und denen die GmbH einen be-
noch aus. Sie gilt jedoch als sicher.
trieblichen Pkw aufgrund dienstvertragli-
4. Kosten für Corona-Tests cher Vereinbarungen auch zur Privatnut-
zung überlässt.
Übernimmt der Arbeitgeber die Kosten von
Covid-19-Tests (PCR- und Antikörper- 6. Sofortabschreibung für digitale
Tests), wird es von der Finanzverwaltung Wirtschaftsgüter
nicht beanstandet, von einem ganz über-
wiegend eigenbetrieblichen Interesse des Aktuelle Rechtslage
Arbeitgebers auszugehen. Die Kostenüber-
Nach aktueller Rechtslage können die An-
nahme ist damit kein Arbeitslohn. Dies hat
schaffungs- oder Herstellungskosten ge-
das Bundesfinanzministerium (BMF) kürz-
ringwertiger Wirtschaftsgüter bis zu einem
lich klargestellt.
Betrag von 800 € netto sofort abgeschrie-
5. Privatnutzung eines Firmenwa- ben werden. Bei teureren Wirtschaftsgü-
tern können die Kosten nur in Höhe der Ab-
gens
schreibung verteilt über die Nutzungsdauer
Immer wieder kommt es mit den Finanzäm- geltend gemacht werden.
tern zum Streit über die Besteuerung eines
privaten Nutzungsvorteils aus der Überlas-
sung eines Firmenwagens.
5Finanzverwaltung schafft Ausnahmere- 8. Erleichterungen für freiwillige Hel-
gelung für digitale Wirtschaftsgüter fer in Impfzentren
Vor dem Hintergrund der Corona-Pande- Nach der Abstimmung zwischen Bund und
mie ermöglicht die Finanzverwaltung nun Ländern gilt für all diejenigen, die direkt an
eine sofortige Abschreibung bestimmter di- der Impfung beteiligt sind – also in Aufklä-
gitaler Wirtschaftsgüter unabhängig von rungsgesprächen oder beim Impfen selbst
der 800 €-Grenze. Ermöglicht wird dies – die Übungsleiterpauschale. D. h. entspre-
durch die Annahme einer fiktiven Nut- chende Vergütungen für die freiwillige Tä-
zungsdauer von einem Jahr. Nach dem tigkeit bleiben bis zu einer Höhe von 3000
kürzlich veröffentlichten BMF-Schreiben € steuerfrei.
gilt die Ausnahmeregelung sowohl für
Wer sich wiederum in der Verwaltung und
• Kosten für Computerhardware (z.B. der Organisation von Impfzentren enga-
Laptop, Docking-Station, externe giert, kann die Ehrenamtspauschale i.H.
Speicher, etc.) als auch von 840 € in Anspruch nehmen.
• Software zur Dateneingabe und – Hinweis: Sowohl Übungsleiter- als auch
verarbeitung (inkl. ERP-Systeme). Ehrenamtspauschale greifen lediglich bei
Die Regelung greift außerdem nicht nur für Vergütungen aus nebenberuflichen Tätig-
in 2021 angeschaffte Wirtschaftsgüter. Di- keiten. Dabei können jedoch auch solche
gitale Wirtschaftsgüter die in früheren Jah- Helfer nebenberuflich tätig sein, die keinen
ren angeschafft wurden, sind ebenfalls be- Hauptberuf ausüben, etwa Studenten oder
günstigt. Bei ihnen kann der steuerliche Rentner. Zudem muss es sich beim Arbeit-
Restbuchwert in 2021 vollständig abge- geber oder Auftraggeber entweder um eine
schrieben werden. gemeinnützige Einrichtung oder eine juris-
tische Person des öffentlichen Rechts (bei-
7. Verlängerung der Steuererklä- spielsweise Bund, Länder, Gemeinden)
rungsfristen handeln.
Aufgrund der aktuellen Situation sind die
9. Weitere Informationen
Abgabefristen für die Steuererklärungen
2019 vom 28. Februar 2021 auf den 31. Au- Die vorstehenden Ausführungen und Bei-
gust 2021 verschoben worden. träge sind nach bestem Wissen und Kennt-
nisstand verfasst worden. Es handelt sich
Hinweis: Die Verlängerung greift nur für
nicht um abschließende Informationen und
durch einen Steuerberater oder anderen
ersetzt keine Beratung. Eine Haftung für
Angehörigen der steuerberatenden Berufe
den Inhalt dieses Informationsbriefs kann
(z.B. Lohnsteuerhilfeverein) vertretene
daher nicht übernommen werden.
Steuerpflichtige.
Gerne beraten wir Sie zu diesen und ande-
Außerdem wurde der Beginn des Verzin-
ren Themen.
sungszeitraums für 2019 vom 1. April 2021
auf den 1. Oktober 2021 verschoben. Bitte vereinbaren Sie bei Interesse einen
Besprechungstermin. Wir analysieren indi-
viduell Ihre persönliche Situation, zeigen
Ihnen Vor- und Nachteile auf und geben
Ihnen Gestaltungsempfehlungen.
6Sie können auch lesen